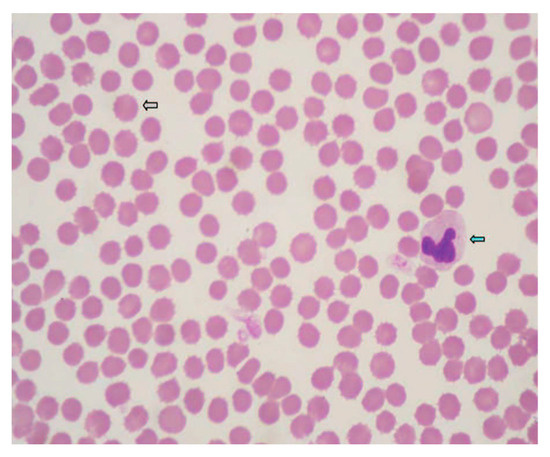

Journal Description
Pets
Pets
is an international, peer-reviewed, open access journal on companion animals published quarterly online by MDPI.
- Open Access— free for readers, with article processing charges (APC) paid by authors or their institutions.
- High Visibility: indexed within Scopus and other databases.
- Rapid Publication: manuscripts are peer-reviewed and a first decision is provided to authors approximately 27.3 days after submission; acceptance to publication is undertaken in 4.7 days (median values for papers published in this journal in the second half of 2025).
- Recognition of Reviewers: APC discount vouchers, optional signed peer review, and reviewer names published annually in the journal.
- Journal Cluster of Animal Science: Animals, Arthropoda, Birds, Insects, Journal of Zoological and Botanical Gardens, Pets, Poultry, Ruminants and Veterinary Sciences.
Latest Articles
Characterization of Clinical, Hematological, and Biochemical Findings in Dogs with Vipera aspis Envenomation
Pets 2026, 3(1), 5; https://doi.org/10.3390/pets3010005 - 20 Jan 2026
Abstract
►
Show Figures
Viper envenomation in dogs represents a significant medical emergency in regions where vipers are endemic. Despite its clinical relevance, detailed data on the haematological and biochemical alterations in canine viper envenomation remain limited. This study aimed to evaluate the clinical presentation and haematological,
[...] Read more.
Viper envenomation in dogs represents a significant medical emergency in regions where vipers are endemic. Despite its clinical relevance, detailed data on the haematological and biochemical alterations in canine viper envenomation remain limited. This study aimed to evaluate the clinical presentation and haematological, biochemical and coagulative changes occurring in dogs following bites from the Vipera aspis species, and to assess their diagnostic and prognostic significance. Twelve dogs with suspected Vipera aspis envenomation were encompassed in the study. Clinical data were gathered and blood samples were collected at hospital admission (T1), 24 h (T2) and 48 h later (T3). Complete blood counts, biochemical profiles and coagulation parameters were analysed using standard automated systems. Common clinical signs included local pain and swelling, depression, fever, haematuria and melena. Haematological evaluation revealed progressive anaemia, leucocytosis and thrombocytopenia. Biochemical findings showed elevated alanine aminotransferase (ALT), aspartate aminotransferase (AST), alkaline phosphatase (ALP) and creatine kinas (CK), indicating hepatic and muscular injury; however, no consistent evidence of renal failure was found. Coagulation analysis revealed a significant shortening of activated partial thromboplastin time (aPTT) and prothrombin time (PT) over time, alongside marked increases in fibrinogen and antithrombin III. This indicates an inflammatory rather than consumptive coagulopathy. Viper envenomation in dogs induces complex haematological and biochemical alterations, reflecting both direct venom toxicity and systemic inflammatory responses. Early recognition, supportive care and continuous laboratory monitoring are essential for improving prognosis.
Full article
Open AccessCase Report
Successful Management of a Dog with Protein-Losing Enteropathy and Concurrent Protein-Losing Nephropathy with Repeated Fecal Microbiota Transplantation
by
Alexander Schreiber, Chih-Chun Chen, Jan S. Suchodolski and Betty Chow
Pets 2026, 3(1), 4; https://doi.org/10.3390/pets3010004 - 19 Jan 2026
Abstract
►▼
Show Figures
Protein-losing enteropathy (PLE) is a spectrum of gastrointestinal disorders in which protein loss occurs through the gastrointestinal tract. One of the underlying causes is chronic inflammatory enteropathy (CIE). Conventional therapies for CIE often include diet, immunosuppressives, anti-microbials, probiotics, and, recently, fecal microbial transplantation
[...] Read more.
Protein-losing enteropathy (PLE) is a spectrum of gastrointestinal disorders in which protein loss occurs through the gastrointestinal tract. One of the underlying causes is chronic inflammatory enteropathy (CIE). Conventional therapies for CIE often include diet, immunosuppressives, anti-microbials, probiotics, and, recently, fecal microbial transplantation (FMT). This case report highlights the use of lyophilized material-based FMT through oral capsules and enema in a dog with PLE and concurrent protein-losing nephropathy (PLN). The patient initially had a significantly increased dysbiosis index (DI) and required repeated FMT treatments, resulting in a positive clinical response through improvement in body weight, serum albumin concentrations, fecal scores, and normalization of the DI over time. To maintain clinical responses, FMT had to be performed monthly. Approximately 1 year after starting FMT therapy, the patient then developed an episode of acute hemorrhagic diarrhea syndrome (AHDS) associated with netF-gene-encoding Clostridium perfringens strains, after which the DI became abnormal again. The patient responded clinically well to monthly FMT treatments again, but it took several months for normalization of the DI after the AHDS episode. In summary, this case report highlights the continued use of adjunct lyophilized FMT in a dog with PLE resulting in improved clinical control over time.
Full article

Figure 1
Open AccessArticle
Squamous Cell Carcinomas in Cats: A Retrospective Study of 4300 Histopathological Cases (2017–2023)
by
Anna-Chiara Riedl, Katharina Charlotte Jensen, Katja Schirl, Ines Hoffmann, Joshua Schwinn, Robert Klopfleisch and Heike Aupperle-Lellbach
Pets 2026, 3(1), 3; https://doi.org/10.3390/pets3010003 - 11 Jan 2026
Abstract
►▼
Show Figures
This retrospective study provides an extensive evaluation of feline squamous cell carcinoma (SCC), comparing oral and cutaneous SCC, as well as different oral/cutaneous sites, with respect to sex, age, breed, and coat length. It was based on 4300 SCCs submitted to LABOKLIN GmbH
[...] Read more.
This retrospective study provides an extensive evaluation of feline squamous cell carcinoma (SCC), comparing oral and cutaneous SCC, as well as different oral/cutaneous sites, with respect to sex, age, breed, and coat length. It was based on 4300 SCCs submitted to LABOKLIN GmbH & Co. KG from 2017 to 2023. No sex predisposition was identified. Affected cats were predominantly older (median age 13 years). SCC risk increased with age, although cats of very young age were also affected. Breed predispositions were not found. However, compared to non-pedigree cats, Persians, Norwegian Forest Cats, British Shorthairs (BSH), Chartreux, and Siamese cats showed a reduced risk, as did longhaired cats. The predominant sites were the oral cavity (41.0%, 1762/4300) and skin (35.8%, 1540/4300). Maine Coons, BSHs, Persians, and Norwegian Forest Cats, as well as longhaired cats, developed oral SCC more frequently. Intraoral, gingival (36.2%, 637/1762) and lingual (19.0%, 334/1762) SCC predominated. Common cutaneous sites included the pinnae (35.0%, 539/1540), unspecified head/neck regions (8.8%, 135/1540), and the nose (8.7%, 134/1540). Maine Coons and BSHs showed less auricular SCC; Sphynx had more on the trunk. These findings emphasise SCC as a crucial differential diagnosis for oral and cutaneous lesions, even in young cats.
Full article

Figure 1
Open AccessSystematic Review
A Systematic Review of Pet Attachment and Health Outcomes in Older Adults
by
Erika Friedmann, Nancy R. Gee, Mona Ramadan Abdelhamed Eltantawy and Sarah Cole
Pets 2026, 3(1), 2; https://doi.org/10.3390/pets3010002 - 7 Jan 2026
Abstract
►▼
Show Figures
Research suggests that older adults might obtain health benefits from pet ownership; however, results are mixed. Pet attachment is suggested as both a mechanism for the relationship and a reason for differences in the association of pet ownership with health outcomes. This systematic
[...] Read more.
Research suggests that older adults might obtain health benefits from pet ownership; however, results are mixed. Pet attachment is suggested as both a mechanism for the relationship and a reason for differences in the association of pet ownership with health outcomes. This systematic review examines evidence for the relationship between pet attachment and health outcomes among older adults. The Open Science Foundation-registered review began with 20,795 candidate articles. We limited our review to the 58 articles that consisted of original research, published in peer-reviewed journals between 1965 and June 2025, written in English, included older adults (age ≥ 50 years) or were limited to only older adults, and examined the relationship between pet attachment and health outcomes. The articles included analyses of psychological (n = 53), social (n = 27), or physical (n = 2) health outcomes. Pet attachment was assessed with 19 tools; most frequently the Lexington Attachment to Pets Scale (n = 21) and the Pet Attachment Questionnaire (n = 8). The studies were not consistently of high quality according to OCEBM criteria. Except for grief, which was consistently related to pet attachment, the findings do not support a clear relationship between pet attachment and health outcomes in older adults. Findings suggest that the relationship between pet attachment and health outcomes may be more pronounced in younger than in older adults.
Full article

Figure 1
Open AccessArticle
Effect of a Supplement Containing Probiotics, Prebiotics, and Yeast Extract on Gut Inflammation, Microbiota, and Cytokines in Healthy Dogs
by
Angela Zilinger, Mary K. Sramek, Tarun Chandra, Teresa Schmidt, Jessica Bagel, Andrew Stayduhar, James Fryer and Gregory D. Sunvold
Pets 2026, 3(1), 1; https://doi.org/10.3390/pets3010001 - 4 Jan 2026
Abstract
►▼
Show Figures
Probiotics, prebiotics, and postbiotics are of interest for their potential gastrointestinal and immunological benefits in pet health. This study aimed to assess whether a unique blend of Bacillus subtilis, Bacillus clausii, Bacillus coagulans (Weizmannia coagulans), FOS, GOS, and a
[...] Read more.
Probiotics, prebiotics, and postbiotics are of interest for their potential gastrointestinal and immunological benefits in pet health. This study aimed to assess whether a unique blend of Bacillus subtilis, Bacillus clausii, Bacillus coagulans (Weizmannia coagulans), FOS, GOS, and a postbiotic yeast extract could provide beneficial gut and immunological effects when fed to healthy, adult dogs. Twenty-four healthy adult beagle dogs (mean age 5.17 yrs) were fed the probiotic, prebiotic, and yeast chew (PPYC) or control chew (CC) supplement for 31 days, accompanied by fecal and blood sampling. Following 31 days, PPYC fed dogs had decreased (p < 0.05) fecal calprotectin concentration, a biomarker indicative of reduced intestinal inflammation, compared with dogs receiving the CC. In the PPYC group, blood C-reactive protein levels, an indicator of tissue inflammation, tended (p = 0.11) to be reduced. In addition, dogs receiving the PPYC supplement showed an increase in the IL-17a cytokine (p < 0.05). Despite dogs being in a clinically healthy state, changes in some dysbiosis-related bacterial strains were observed. There was an increase (p < 0.05) in the % of total bacteria of Blautia in the PPYC group by the end of the study, as well as an increase in the percent change from Day 0 of C. hiranosis (p < 0.05). Increased alpha diversity, a measure related to the resilience to environmental change, was observed in the PPYC group (p < 0.05). These results suggest that after consuming a supplement containing probiotics, prebiotics and a postbiotic yeast extract, markers of gut and systemic health were improved in otherwise healthy dogs.
Full article

Figure 1
Open AccessBrief Report
DEA 1 Prevalence and Theoretical Transfusion Mismatch Estimates in Dogs from Southeastern Mexico
by
Carlos Antonio Arcos-Roa, Luis Arturo Ortíz-Carbajal, Jose Luis Bravo-Ramos, María Guadalupe Sánchez-Otero, Sokani Sánchez-Montes, Aarón Bustos-Baena, Carolina Palmeros-Exsome, Sashenka Bonilla-Rojas and Beatriz Agame-Lagunes
Pets 2025, 2(4), 43; https://doi.org/10.3390/pets2040043 - 18 Dec 2025
Abstract
►▼
Show Figures
Ensuring blood group compatibility is essential in canine transfusion medicine, and Dog Erythrocyte Antigen (DEA) 1 is the most clinically relevant erythrocyte antigen due to its immunogenicity. However, information on its prevalence in Mexico is scarce. This study assessed the distribution of DEA
[...] Read more.
Ensuring blood group compatibility is essential in canine transfusion medicine, and Dog Erythrocyte Antigen (DEA) 1 is the most clinically relevant erythrocyte antigen due to its immunogenicity. However, information on its prevalence in Mexico is scarce. This study assessed the distribution of DEA 1 in client-owned dogs from Veracruz–Boca del Río, southeastern Mexico, and applied antigen frequencies to generate theoretical incompatibility scenarios in untyped populations. A cross-sectional study was conducted using blood samples from 192 clinically healthy dogs. DEA 1 typing was performed using a commercial immunochromatographicassay. Frequencies were compared using chi-square or Fisher’s exact test, and 95% confidence intervals were calculated with the Wilson method. Of all dogs sampled, 60.9% (95% CI: 53.6–67.8) were DEA 1-positive. No statistically significant differences were observed by sex or municipality (p > 0.05). Although frequencies varied among breeds, no significant association between breed and DEA 1 status was detected (p > 0.05). Based on observed antigen proportions, mathematical estimations were calculated to illustrate how DEA 1 distribution alone may contribute to potential donor–recipient mismatching when typing is not performed. These estimations are theoretical values and do not represent clinically documented sensitization or transfusion reactions. This study provides the first report of DEA 1 distribution in southeastern Mexico and establishes baseline information that may support future research on canine transfusion practices and donor selection.
Full article

Graphical abstract
Open AccessArticle
Exploring Factors of Dog Temperament Impacting Pass/Fail Outcomes in Therapy Dog Aptitude Tests
by
Shiori Kawai, Saki Terashima, Natsuki Ebashi, Mayu Sakurama, Miki Ito, Yumiko Nakanowataru and Takanori Kooriyama
Pets 2025, 2(4), 42; https://doi.org/10.3390/pets2040042 - 6 Dec 2025
Abstract
►▼
Show Figures
In recent years, requests for animal-assisted interventions (AAI) from medical institutions and welfare facilities have increased. Dogs are the most commonly used animals in AAI. Dogs that pass the “therapy dog” aptitude test can work in AAI. In previous research, we identified the
[...] Read more.
In recent years, requests for animal-assisted interventions (AAI) from medical institutions and welfare facilities have increased. Dogs are the most commonly used animals in AAI. Dogs that pass the “therapy dog” aptitude test can work in AAI. In previous research, we identified the Canine Behavior Assessment and Research Questionnaire (C-BARQ) factors common among dogs that passed the aptitude test. Using these factors, we developed the TC-BARQ, a screening questionnaire for therapy dogs that included 51 C-BARQ surveys. In this study, we conducted TC-BARQ screenings and compared the characteristics of dogs that passed and failed the aptitude test. We collected TC-BARQ data points from aptitude test examinees of the local AAI Dog Association. Each dog is identified by its breed, sex, neutering status, and whether it lives with another dog at home. For each question, we identified factors that differed between dogs that passed and those that failed. As a result, differences emerged in the presence of family dogs, particularly in behaviors related to aggression toward strangers and other dogs, as well as excitability toward people and situations. Continued surveillance is essential, but this study provides important information on selecting “therapy dogs”.
Full article

Figure 1
Open AccessReview
Myocutaneous Flaps and Muscle Flaps for Management of Limbs’ Defects in Dogs and Cats: A Review
by
Mandalena Markou, Eleftheria Dermisiadou, Konstantina Karagianni, Eugenia Flouraki and Vassiliki Tsioli
Pets 2025, 2(4), 41; https://doi.org/10.3390/pets2040041 - 5 Dec 2025
Abstract
►▼
Show Figures
The objective of the present study is to review the anatomical considerations, surgical techniques, clinical applications, and outcomes of myocutaneous and muscle flaps used in the reconstruction of limb defects in dogs and cats. Limb wounds in small animals often result from trauma,
[...] Read more.
The objective of the present study is to review the anatomical considerations, surgical techniques, clinical applications, and outcomes of myocutaneous and muscle flaps used in the reconstruction of limb defects in dogs and cats. Limb wounds in small animals often result from trauma, neoplasia, or infection and can involve significant soft tissue loss. Reconstruction of these defects is challenging due to limited local skin availability, particularly in distal regions, and the need to preserve function while preventing complications. Muscle and myocutaneous flaps provide well-vascularized tissue suitable for covering complex wounds, especially those with exposed bone, joints, or tendons. This review synthesizes current literature on commonly used flaps—including latissimus dorsi, cutaneous trunci, trapezius, sartorius, semitendinosus, and flexor carpi ulnaris; focusing on their anatomical basis, vascular supply, arc of rotation, surgical technique, indications, and complication rates. Comparative data between dogs and cats are highlighted, and experimental as well as clinical applications are discussed. Myocutaneous flaps offer durable and reliable coverage with lower infection and necrosis rates compared to skin grafts, particularly in contaminated or poorly vascularized wounds. Common complications include distal flap necrosis, wound dehiscence, seroma, and, occasionally, functional deficits. Muscle and myocutaneous flaps remain essential tools in limb reconstruction. Successful outcomes require careful flap planning, surgical expertise, and vigilant postoperative care. Further prospective studies are needed to optimize flap selection and reduce complication rates in both species.
Full article

Figure 1
Open AccessCommentary
Emotional Support? Law, Social Control, and the Medicalization of the Human–Animal Bond
by
Nicole R. Pallotta
Pets 2025, 2(4), 40; https://doi.org/10.3390/pets2040040 - 14 Nov 2025
Abstract
In recent years, the socio-legal concept of emotional support animals (ESAs) has come under increasing scrutiny in the U.S. Widespread confusion about the legal status of ESAs versus service animals and concerns about misrepresentation have resulted in a backlash and a cascade of
[...] Read more.
In recent years, the socio-legal concept of emotional support animals (ESAs) has come under increasing scrutiny in the U.S. Widespread confusion about the legal status of ESAs versus service animals and concerns about misrepresentation have resulted in a backlash and a cascade of new legislation addressing “fake service animals.” However, this reaction reveals a broader social problem rooted in policy lag: the integration of companion animals into society has not kept pace with the rise of multispecies families. This article examines law, policy, and public discourse about ESAs within two distinct social contexts: (1) the emergence of multispecies families alongside the systemic exclusion of companion animals from many private and public spaces, and (2) the medicalization of relational bonds and everyday life. Although well-intentioned, the legal and social construction of ESAs creates a two-tiered system where caregivers of companion animals must acquire a medical diagnosis in order to obtain equal access to basic necessities like housing. In addition to resting on weak evidence, the ESA framework diverts attention from macro social issues by pathologizing the individual, creating a problematic medicalization of the human-animal bond that is ultimately detrimental to the well-being of companion animals, their caregivers, and people with disabilities. The construct is also troublingly anthropocentric, centering what animals can do for humans without considering the psychological and emotional support needs of the animals themselves. This article concludes that the anthropocentric medical model advanced by the ESA construct should be replaced with a multispecies social model that supports the human-animal bond without unnecessary medicalization. This approach advocates for equitable laws and policies, such as the expansion of pet-inclusive housing, that benefit families that include companion animals and the communities in which they are embedded.
Full article
Open AccessArticle
Self-Medication Practices for Companion Animals in Japan: A Descriptive Survey of Pet Owners’ Use of Over-the-Counter Drugs and Perspectives on Pharmaceutical Care
by
Taisuke Konno, Daisuke Kikuchi, Hiroyuki Suzuki, Yosuke Nishikawa, Shigeki Kisara, Hitoshi Nakamura and Yuriko Murai
Pets 2025, 2(4), 39; https://doi.org/10.3390/pets2040039 - 2 Nov 2025
Abstract
►▼
Show Figures
Owner-led self-medication for companion animals is a growing global practice; however, empirical data from Japan remain limited. Framing medication safety within a One Health perspective, this study aimed to characterize Japanese pet owners’ use of over-the-counter (OTC) drugs and identify possibilities for pharmacists
[...] Read more.
Owner-led self-medication for companion animals is a growing global practice; however, empirical data from Japan remain limited. Framing medication safety within a One Health perspective, this study aimed to characterize Japanese pet owners’ use of over-the-counter (OTC) drugs and identify possibilities for pharmacists to support rational self-medication. A cross-sectional 13-item online survey was administered to 500 owners in Japan between 30 May and 2 June 2025. Data on owner demographics, willingness to consult pharmacists, veterinary visit behavior, and OTC purchasing practices were summarized. Many owners were receptive to pharmacy support; 65% wished to consult a pharmacist, and 6.8% had already done so. Overall, 15.2% reported using OTCs drugs, primarily for treatment or prevention and prioritized perceived effectiveness and safety when selecting products. Some owners managed mild pet illnesses at home, citing perceived mildness and cost as reasons for not visiting a veterinary clinic. There is an unmet demand for accessible expert counseling at the point of purchase. Leveraging community pharmacies linked with pet specialty pharmacies as first-contact hubs could promote appropriate self-medication; doing so would require veterinary-specific training, establishing a formal credential for veterinary pharmacists, and defining pharmacist–veterinarian communication to ensure safe and effective use.
Full article

Figure 1
Open AccessReview
Review of the Use of Pre-Visit Pharmaceuticals for Reducing Fear-Related Behaviours in Dogs
by
Aimee Clark and Kristie E. Cameron
Pets 2025, 2(4), 38; https://doi.org/10.3390/pets2040038 - 27 Oct 2025
Abstract
Fear, anxiety, and stress (FAS) in canine patients is a growing concern for the veterinary industry. FAS affects the health of the patient while also increasing the risk to veterinary staff. Studies show that many veterinarians do not feel confident in managing behavioural
[...] Read more.
Fear, anxiety, and stress (FAS) in canine patients is a growing concern for the veterinary industry. FAS affects the health of the patient while also increasing the risk to veterinary staff. Studies show that many veterinarians do not feel confident in managing behavioural issues like FAS, making engaging effectively with clients more difficult. Pre-visit pharmaceuticals (PVPs) can be an important tool in mitigating the effects of FAS; however, conclusive research is lacking on the efficacy of many of the medications and combinations currently used for this purpose. A comprehensive literature search was conducted in multiple databases. The most current research available on medications identified as widely used for treating FAS, and available for use in New Zealand, has been reviewed and discussed. Combinations selected for inclusion were the ‘chill protocol’ of acepromazine, gabapentin, and melatonin. Single agents included are clonidine, dexmedetomidine, gabapentin, and trazodone. Research into the use of the ‘chill protocol’ suggests this may be a combination particularly useful in highly stressed and aggressive dogs; however, additional studies need to be conducted to strengthen the evidence for its use. A multimodal approach has been identified as being desirable when addressing FAS in a clinical setting, with less evidence to support the use of single-agent medications in mitigating problematic behaviours.
Full article
Open AccessCorrection
Correction: Redmond et al. Evaluating the Effects of Novel Enrichment Strategies on Dog Behaviour Using Collar-Based Accelerometers. Pets 2025, 2, 23
by
Cushla Redmond, Ina Draganova, Rene Corner-Thomas, David Thomas and Chris Andrews
Pets 2025, 2(4), 37; https://doi.org/10.3390/pets2040037 - 15 Oct 2025
Abstract
In the original publication [...]
Full article
Open AccessArticle
Histopathological Study of Canine Skin Hemangiomas and Hemangiosarcomas in Uruguay
by
Belén Varela, Camila Larrañaga, Victoria Yozzi, Kanji Yamasaki and José Manuel Verdes
Pets 2025, 2(4), 36; https://doi.org/10.3390/pets2040036 - 15 Oct 2025
Abstract
We performed an histological study on all cases of canine skin hemangiomas and hemangiosarcomas that were examined between 2018 and 2020. Of the 446 dogs with skin tumors examined, 25 were diagnosed with hemangiomas and 24 were diagnosed with hemangiosarcomas. Mixed-breed dogs were
[...] Read more.
We performed an histological study on all cases of canine skin hemangiomas and hemangiosarcomas that were examined between 2018 and 2020. Of the 446 dogs with skin tumors examined, 25 were diagnosed with hemangiomas and 24 were diagnosed with hemangiosarcomas. Mixed-breed dogs were the most commonly affected by both tumors. The average ages of the dogs who were diagnosed with hemangiomas and hemangiosarcomas were 8.70 and 8.36 years, respectively, with the mean age for hemangiosarcomas being slightly higher; however, this difference was not statistically significant. Both types of tumors were more common in the trunk and limbs. Sex differences in tumor frequency were not detected in dogs with hemangiomas or hemangiosarcomas. Histologically, the mixed capillary and cavernous type was the most common in cases of hemangiomas, and the mixed capillary, cavernous, and solid type and the mixed cavernous and solid type were more common in hemangiosarcoma cases compared with the other types. In addition, epithelioid hemangiosarcomas were frequently detected.
Full article
(This article belongs to the Special Issue Pathology in Companion Animals—From Diagnostics to Treatment)
►▼
Show Figures

Figure 1
Open AccessArticle
Occurrence and Characteristics of Salmonella spp., L. monocytogenes, Y. enterocolitica, and Campylobacter spp. in Raw Meat-Based Diets for Pets
by
Désirée Tahnee Schmid, Karen Barmettler, Marc J. A. Stevens and Roger Stephan
Pets 2025, 2(4), 35; https://doi.org/10.3390/pets2040035 - 7 Oct 2025
Abstract
►▼
Show Figures
Raw meat-based diets (RMBDs) have gained popularity over the past few years. However, there is growing concern about their safety. The study objective was to evaluate the prevalence and characteristics of the pathogens Salmonella spp., Listeria monocytogenes, Yersinia enterocolitica, and Campylobacter
[...] Read more.
Raw meat-based diets (RMBDs) have gained popularity over the past few years. However, there is growing concern about their safety. The study objective was to evaluate the prevalence and characteristics of the pathogens Salmonella spp., Listeria monocytogenes, Yersinia enterocolitica, and Campylobacter spp. in frozen commercially sold RMBDs. One hundred raw meat-based diet products (meat originating from Switzerland, Germany, Austria, Spain, Scandinavia, South Africa, and Australia) were purchased online or in local stores and identified using culture-based methods. Isolates were further characterized by phenotypic and whole genome sequencing-based methods. In total, 11% (n = 11) of the samples tested positive for Salmonella spp., 41% (n = 41) for L. monocytogenes, 58% (n = 58) for Y. enterocolitica, and 3% (n = 3) for Campylobacter spp. Other than for Salmonella, there are no legal regulations concerning contamination of RMBDs with these zoonotic pathogens. The results of our study show that it is indicated to reconsider the requirements for the microbiological quality of RMBDs and to further raise awareness regarding the risks of handling and feeding RMBDs.
Full article

Figure 1
Open AccessCase Report
Diagnosis, Management, and Long-Term Outcome of Esophageal Plasmacytoma in a Dog
by
Katerina T. Moraiti, Ioanna Papavasileiou, Evgenia Flouraki, Vasiliki Tsioli, Shelley J. Newman, Joao P. Cavasin and Panagiotis G. Xenoulis
Pets 2025, 2(4), 34; https://doi.org/10.3390/pets2040034 - 5 Oct 2025
Abstract
►▼
Show Figures
A nine-year-old, 10.5 kg, female-spayed Poodle-mix dog presented with a five-day history of vomiting and regurgitation. Thoracic radiographs revealed an area with increased opacity within the esophageal lumen. A ductal esophageal lesion with intraluminal extension and mild left axillary lymphadenopathy were detected on
[...] Read more.
A nine-year-old, 10.5 kg, female-spayed Poodle-mix dog presented with a five-day history of vomiting and regurgitation. Thoracic radiographs revealed an area with increased opacity within the esophageal lumen. A ductal esophageal lesion with intraluminal extension and mild left axillary lymphadenopathy were detected on computed tomography. Esophagoscopy revealed a large vascular, obstructive mass with a smooth surface, in the mid part of the esophagus. Endoscopic biopsies were collected, and histopathologic findings were consistent with an inflammatory polyp. Surgical excision of the mass via sternotomy was performed and the mass was sent for histopathologic evaluation. Histopathological examination of the mass revealed an esophageal plasmacytoma with perivascular amyloid deposition, which was confirmed by immunohistochemical staining. There was no evidence of regrowth until 18 months after surgical removal, when evidence of regrowth was identified. The dog had only one episode of vomiting and regurgitation which was resolved after symptomatic treatment.
Full article

Figure 1
Open AccessArticle
Assessing Probiotic Efficacy: Short-Term Impact on Canine Gut Microbiota Using an In Vitro Colonic Fermentation Model
by
Achraf Adib Lesaux, Jonas Ghyselinck, Cindy Duysburgh, Massimo Marzorati, Jonna E. B. Koper and Jake Burlet
Pets 2025, 2(4), 33; https://doi.org/10.3390/pets2040033 - 28 Sep 2025
Abstract
►▼
Show Figures
In dogs, gut microbiome dysbiosis is associated with several health conditions, including gastrointestinal disease. Probiotic supplementation can support a balanced gut microbiome. This study assessed the impact of a probiotic containing a mixture of Lacticaseibacillus casei, Limosilactobacillus fermentum, Levilactobacillus brevis,
[...] Read more.
In dogs, gut microbiome dysbiosis is associated with several health conditions, including gastrointestinal disease. Probiotic supplementation can support a balanced gut microbiome. This study assessed the impact of a probiotic containing a mixture of Lacticaseibacillus casei, Limosilactobacillus fermentum, Levilactobacillus brevis, and Enterococcus faecium on the gut microbiota of six dogs using short-term colonic simulations. Two groups were included, i.e., blank versus supplementation with the test product, and incubated for 48 h. Probiotic-supplemented reactors had significantly greater fermentative activity compared with the blank, as shown by lower pH levels and higher gas pressure after 6 h, 24 h, and 48 h of incubation (p < 0.05 for all). Saccharolytic fermentation also increased, with a significantly higher level of acetate at 24 h and propionate at 6 h, 24 h, and 48 h with the test product versus blank (p < 0.05 for all). There was no significant effect of the test product on alpha-diversity, but beta-diversity analysis revealed a clear separation in the microbial community composition between the test product and blank. Eight bacterial taxa were enriched with test product supplementation, including the probiotic test strains as well as Megamonas and Bacteroides species. This study, using in vitro short-term colon simulations with six canine donors, provides insights into the probiotic characteristics of the test product.
Full article

Graphical abstract
Open AccessReview
Unraveling Feline Myths: A Review About Misperceptions and Beliefs Surrounding Domestic Cat Behavior
by
Daiana de Souza Machado, Rogério Ribeiro Vicentini, Luana da Silva Gonçalves, Suzana Luchesi, Emma Otta and Aline Cristina Sant’Anna
Pets 2025, 2(3), 32; https://doi.org/10.3390/pets2030032 - 9 Sep 2025
Abstract
Despite the growing preference for cats as companion animals, beliefs and misperceptions about them are still common. Cultural and sociodemographic aspects can influence society’s attitudes towards cats, affecting the way they are kept and cared for and, consequently, their welfare. This narrative review
[...] Read more.
Despite the growing preference for cats as companion animals, beliefs and misperceptions about them are still common. Cultural and sociodemographic aspects can influence society’s attitudes towards cats, affecting the way they are kept and cared for and, consequently, their welfare. This narrative review aimed to identify and categorize beliefs and misconceptions about domestic cats commonly described in the scientific literature, particularly those related to behavior, sociality, health, and management, in order to foster critical thinking about these perceptions. Our bibliographic search included three electronic databases (Web of Science, PubMed and Scopus). This review highlights a set of recurrent beliefs of general society reported by the scientific literature, such as the perception of cats as independent and non-social animals, bringers of bad luck, incapable of forming emotional bonds with their guardians, or in need of outdoor access to thrive. Although widespread, many of these beliefs lack empirical support. Identifying and fostering critical reflection on such beliefs can contribute to deconstructing them, improving the guardian–cat relationship and enhancing the welfare of both cats and humans.
Full article
Open AccessArticle
Exploring Associations Between Empathy, Anthropomorphizing, and Psychological Distress in Dog Parents
by
Heather Dye
Pets 2025, 2(3), 31; https://doi.org/10.3390/pets2030031 - 27 Aug 2025
Cited by 1
Abstract
►▼
Show Figures
Dog parents have a strong attachment to their pets and treat them as children. Similarly to the guilt experienced by the parents of human children, dog parents feel guilty when they have to travel or work long hours and leave their dogs at
[...] Read more.
Dog parents have a strong attachment to their pets and treat them as children. Similarly to the guilt experienced by the parents of human children, dog parents feel guilty when they have to travel or work long hours and leave their dogs at home alone. This study examined the empathic tendencies among dog parents and how they are related to dog parent guilt and other mental health symptoms. A sample of 332 dog owners from the United States, stratified by age and sex, was recruited for this study. The sample comprised 168 female and 164 male participants. The Guilt About Dog Parenting Scale (GAPS-D), Depression Anxiety and Stress Scale-21, Interpersonal Reactivity Index, and Dog Anthropomorphism Scale were administered via an online survey. Demographic variables, such as age, sex, race, education level, household income, relationship, and parental status, were also collected. Data were analyzed using descriptive statistics, correlation, and linear regression. As predicted, this study found that empathic tendencies in dog parents are related to guilt, anthropomorphizing, and mental health symptoms. This is the first study to examine empathetic tendencies among dog parents in relation to dog parent guilt. Researchers, educators, social workers, mental health professionals, and veterinarians should inform and educate pet owners about dog parent guilt. This will increase the knowledge of professionals, organizations, and pet owners suffering from such guilt. Cognitive behavior therapy (CBT) may offer a promising approach for helping pet parents identify, normalize, and better understand their thoughts, feelings, and behaviors related to empathic and anthropomorphic tendencies. By addressing these cognitive patterns, CBT could potentially help reduce associated feelings of guilt, depression, anxiety, and stress.
Full article

Graphical abstract
Open AccessArticle
Effects of Bacillus pumilus SG154 or Lacticaseibacillus paracasei 327 Postbiotic on the Fecal Characteristics and Microbiota of Healthy Adult Dogs Subjected to an Abrupt Diet Change
by
Jocelyn F. Wren, Sofia M. Wilson, Yifei Kang, Patrícia M. Oba, John F. Menton, Elena Vinay, Mathieu Millette, Melissa R. Kelly and Kelly S. Swanson
Pets 2025, 2(3), 30; https://doi.org/10.3390/pets2030030 - 14 Aug 2025
Abstract
Background: Abrupt dietary changes may disrupt gut microbiota populations and lead to gastrointestinal issues. This study aimed to determine the effects of live Bacillus pumilus SG154 or Lacticaseibacillus paracasei 327 postbiotic on fecal characteristics and microbiota populations of dogs following an abrupt diet
[...] Read more.
Background: Abrupt dietary changes may disrupt gut microbiota populations and lead to gastrointestinal issues. This study aimed to determine the effects of live Bacillus pumilus SG154 or Lacticaseibacillus paracasei 327 postbiotic on fecal characteristics and microbiota populations of dogs following an abrupt diet change. Methods: Twelve healthy adult English pointer dogs (6.38 ± 2.75 yr) were used in a replicated 3 × 3 Latin square design to test the following treatments: (1) placebo (control; 250 mg maltodextrin/d); (2) live B. pumilus [5 × 109 colony-forming units (CFU)/d]; and (3) L. paracasei postbiotic (100 mg; derived from 2 × 109 CFU/d). Each period lasted 42 days, with the diet change occurring on day 28. Fecal samples were scored and analyzed for pH, dry matter content, and microbiota before and 2, 6, 10, and 14 days after the diet change. Results: The abrupt diet change increased (p < 0.01) fecal pH, increased (p < 0.01) the dysbiosis index, decreased (p < 0.0001) fecal dry matter, and led to a large shift in the fecal microbiota community. Fecal scores were lower (p < 0.05) in the B. pumilus group. B. pumilus reduced (p < 0.05) the relative abundance of fecal Prevotella and Muribaculaceae, while both treatments (B. pumilus; L. paracasei) increased (p < 0.05) the relative abundance of fecal Holdemanella. Conclusions: These results suggest that an abrupt diet change leads to large shifts in fecal microbiota and modified fecal characteristics. The supplementation with a B. pumilus probiotic and a L. paracasei postbiotic slightly altered the relative abundance of a few microbial taxa but was unable to attenuate most responses.
Full article
(This article belongs to the Topic Research on Companion Animal Nutrition)
►▼
Show Figures

Figure 1
Open AccessArticle
Factors Influencing New Zealanders’ Attitudes Towards the Euthanasia of Pets and Feral Animals
by
Leena Awawdeh, Natalie Waran and Rachel H. Forrest
Pets 2025, 2(3), 29; https://doi.org/10.3390/pets2030029 - 14 Aug 2025
Abstract
Objective: To investigate public attitudes in New Zealand towards the euthanasia of dogs and cats and to explore the factors that influence these views. Materials and Methods: Data were collected through a nationwide online survey conducted in 2019 as part of the Furry
[...] Read more.
Objective: To investigate public attitudes in New Zealand towards the euthanasia of dogs and cats and to explore the factors that influence these views. Materials and Methods: Data were collected through a nationwide online survey conducted in 2019 as part of the Furry Whānau Wellbeing research project. The survey included questions about pet euthanasia, and respondents were asked to indicate their level of agreement with various statements. Results: Of 2293 respondents to the 2019 New Zealand Pet Survey, the majority (n = 1756) opposed euthanasia for stray, unwanted, or financially burdensome pets (76.7%; 90.2% and 66.3% of these disagreed or strongly disagreed, respectively). In contrast, a slim majority (n = 1162) supported it for sick animals. Females were less likely to agree with euthanasia in most scenarios compared to males. Māori and New Zealand European respondents (n = 1790) showed higher levels of neutrality than other ethnicities regarding stray animals and lower levels of disagreement regarding financially constrained situations. Older respondents (65+) were more likely to support euthanasia for sick animals, while younger respondents (18–24) were less inclined. Higher education levels are correlated with increased neutrality towards euthanising stray animals and increased support for euthanising feral animals. Respondents with children were more likely to be neutral or to disagree with euthanasia in most scenarios. Those with rural upbringings were more accepting of euthanasia for stray and feral animals. A thematic analysis of 653 respondent comments revealed key themes: euthanasia was seen as complex and context-dependent, a humane last resort for suffering animals, but not for convenience. Respondents emphasised responsible pet ownership and a right to life, even for feral animals, advocating for alternatives such as trap–neuter–release. Conclusion: New Zealanders largely view euthanasia as an ethically acceptable option for terminally ill or suffering animals but reject it when driven by convenience or financial hardship. Attitudes vary across demographic groups, highlighting the need for culturally sensitive education and policy. The findings align with Sustainable Development Goal 3 (Good Health and Well-being) and support broader discussions on responsible pet ownership, ethical decision making, and animal welfare legislation.
Full article
Highly Accessed Articles
Latest Books
E-Mail Alert
News
Topics
Topic in
Animals, Antioxidants, Metabolites, Pets, Veterinary Sciences
Research on Companion Animal Nutrition
Topic Editors: Baichuan Deng, Lian Li, Yun JiDeadline: 26 October 2026
Topic in
Agriculture, Animals, Applied Biosciences, Metabolites, Physiologia, Dairy, Pets
New Perspectives on Metabolism and Metabolic Disease in Wildlife, Domestic, and Exotic Pets and Livestock
Topic Editors: Filipe da Costa Silva, Isabel PiresDeadline: 3 July 2027
Conferences
Special Issues
Special Issue in
Pets
Pathology in Companion Animals—From Diagnostics to Treatment
Guest Editor: Stanisław DzimiraDeadline: 31 July 2026